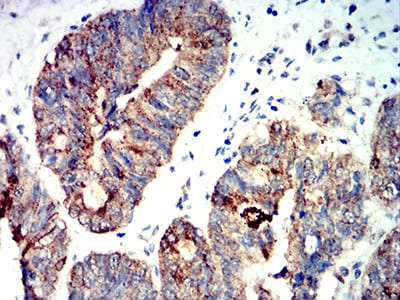

-
分类: 科研抗体货号: 31198别名: GSA7; APG7L; APG7-LIKE应用: FCM反应种属: Human
-
分类: 科研抗体货号: 31182别名: AMY1应用: WB,FCM反应种属: Human,Rat
-
分类: 科研抗体货号: 31187别名:应用: WB,IF反应种属: Human
-
分类: 科研抗体货号: 31197别名: DSH; AGS6; G1P1; IFI4; P136; ADAR1; DRADA; DSRAD; IFI-4; K88DSRBP应用: IF,FCM反应种属: Human
-
分类: 科研抗体货号: 31181别名: APC1; MCPR; TSG24应用: FCM反应种属: Human
-
分类: 科研抗体货号: 31186别名:应用: WB,IF,FCM反应种属: Human
-
分类: 科研抗体货号: 31196别名: DSH; AGS6; G1P1; IFI4; P136; ADAR1; DRADA; DSRAD; IFI-4; K88DSRBP应用: WB,FCM反应种属: Human
-
分类: 科研抗体货号: 31179别名: AMPK; AMPK2; PRKAA; AMPKa2应用: IHC反应种属: Human
-
分类: 科研抗体货号: 31212别名: BCAM; BCT2; PP18; BCATM应用: FCM反应种属: Human
-
分类: 科研抗体货号: 31195别名: JMJD2B; TDRD14B应用: FCM反应种属: Human,Mouse

鄂公网安备42018502007531号
鄂公网安备42018502007531号

